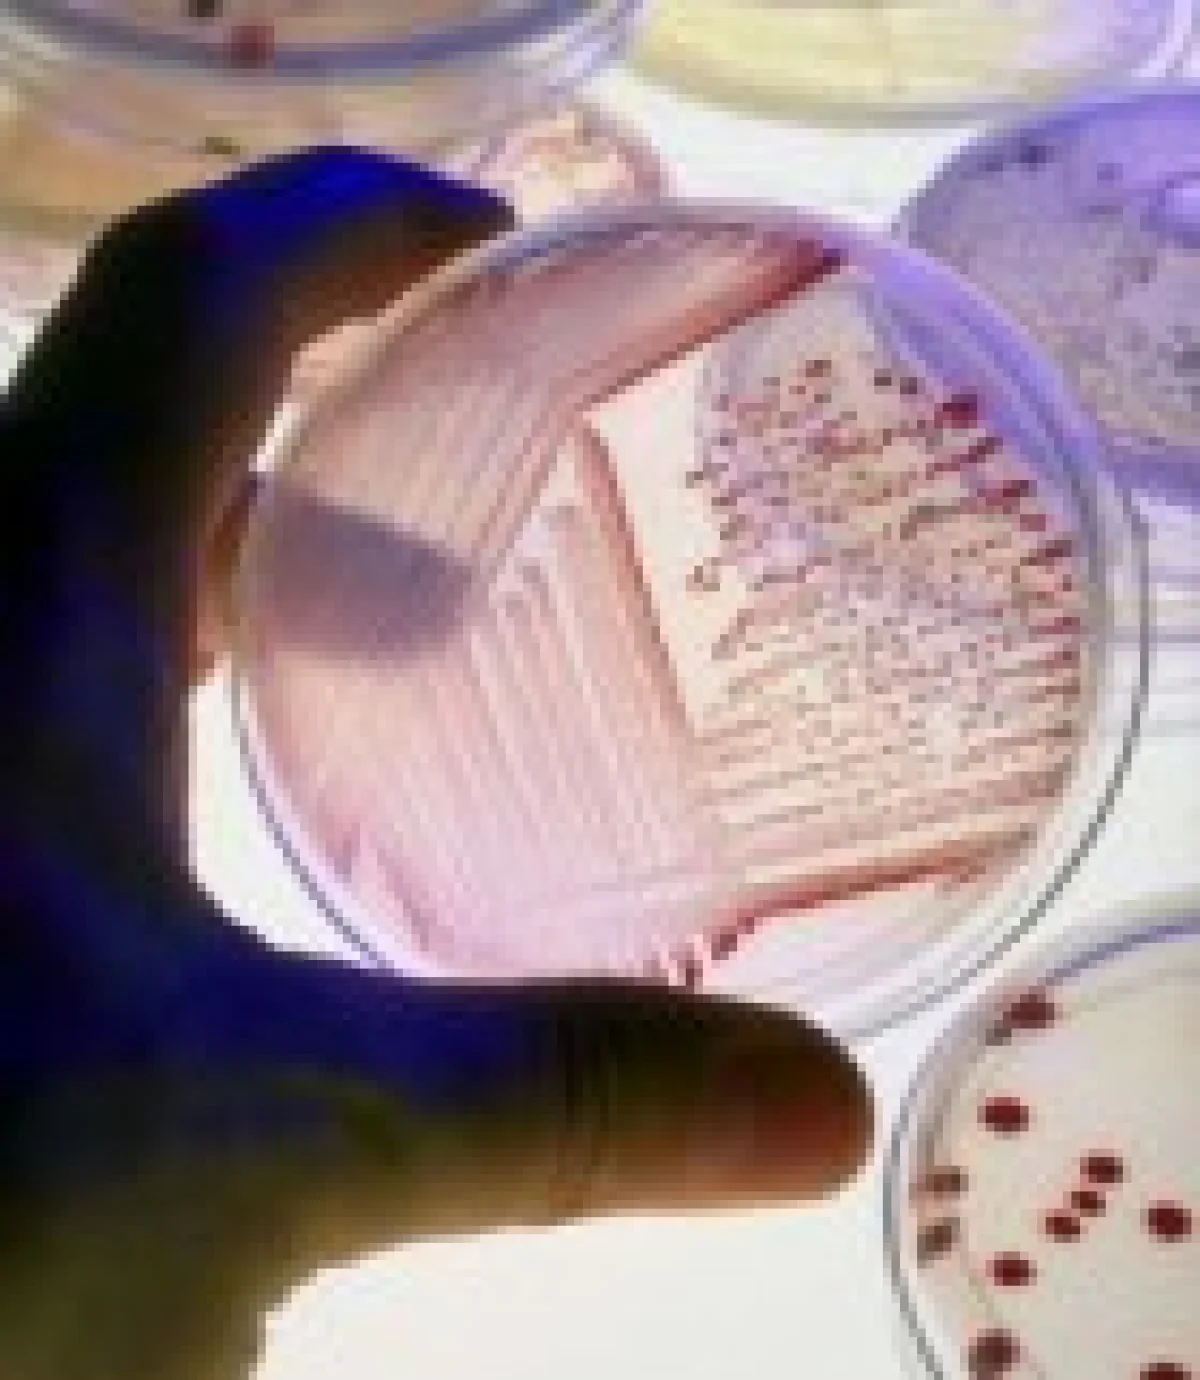

Тульские специалисты проверили кровь сельскохозяйственных животгных
За период с 09.02.16 г. по 20.02.16 г. отделом серологии ФГБУ «Тульская МВЛ» было проведено 3885 исследований крови сельскохозяйственных животных. Для исследования на бруцеллез поступила кровь и сыворотка крови от лошадей, свиней, крупного рогатого скота; от лошадей — на сап, случную болезнь. Проведены исследования на паратуберкулез, хламидиоз, лейкоз, листериоз. Из них по государственному заданию и эпизоотическому мониторингу — 1984 исследования.
Кровь поступала из Тульской, Московской, Липецкой и Калужской областей.
Для исследования свиней на бруцеллез использовали серологический метод — реакцию связывания комплемента (РСК). Этот метод дает высокий результат при обнаружении данной болезни. При серологическом исследовании выявляют антитела — это является самым простым и чаще других использованным, а часто и основным методом обнаружения бруцеллеза у свиней.
В Липецкой области выявлена 61 проба от крупного рогатого скота, серопозитивного на лептоспироз (обнаружены антитела к серогруппам лептоспир).